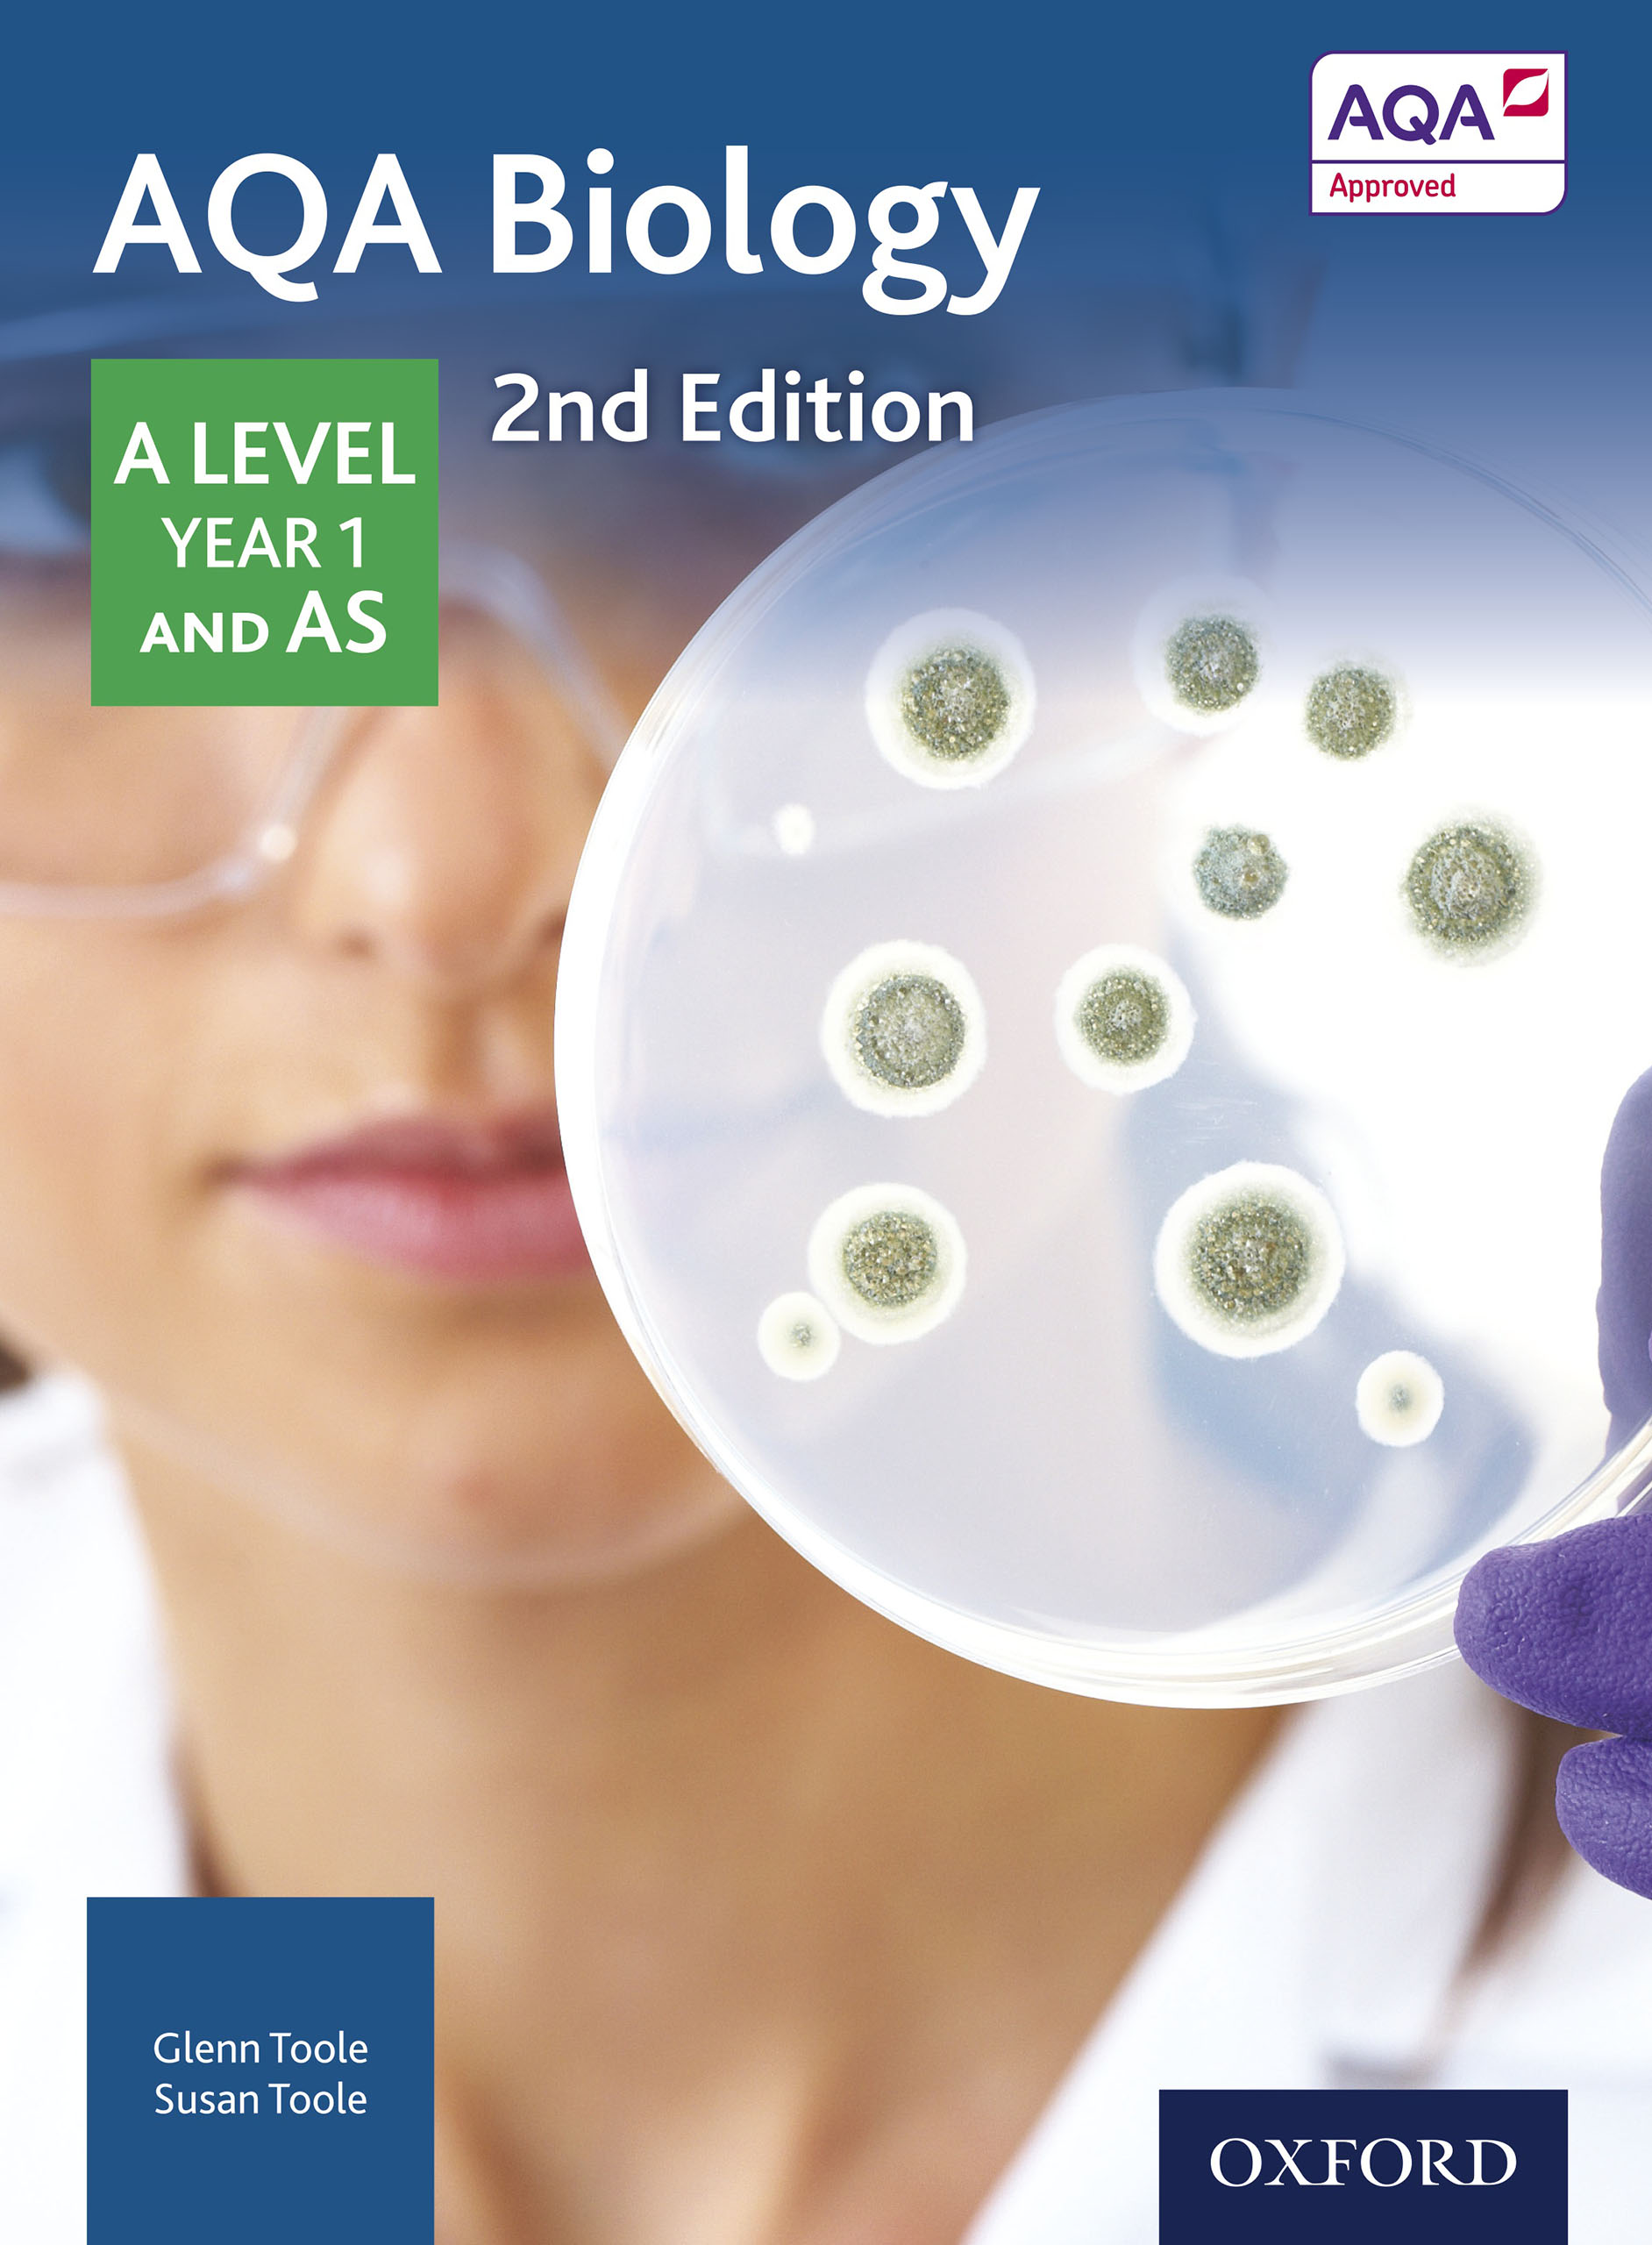

Aqa mature level 2 gcse
Aqa mature level 2 gcse 128 photos
Quick fuck with a pornstar
Young School Nude College Girl
Kell encoxando
Lesbo schoolgirls making out in principals office
Sex asian 24
Very Skinny Girls
Fame Girls Model Porno Foto
Desi Bigg Butt Walk Saree
Xnxn Arabic
Selen Garcia Beyblade Shogun Steel